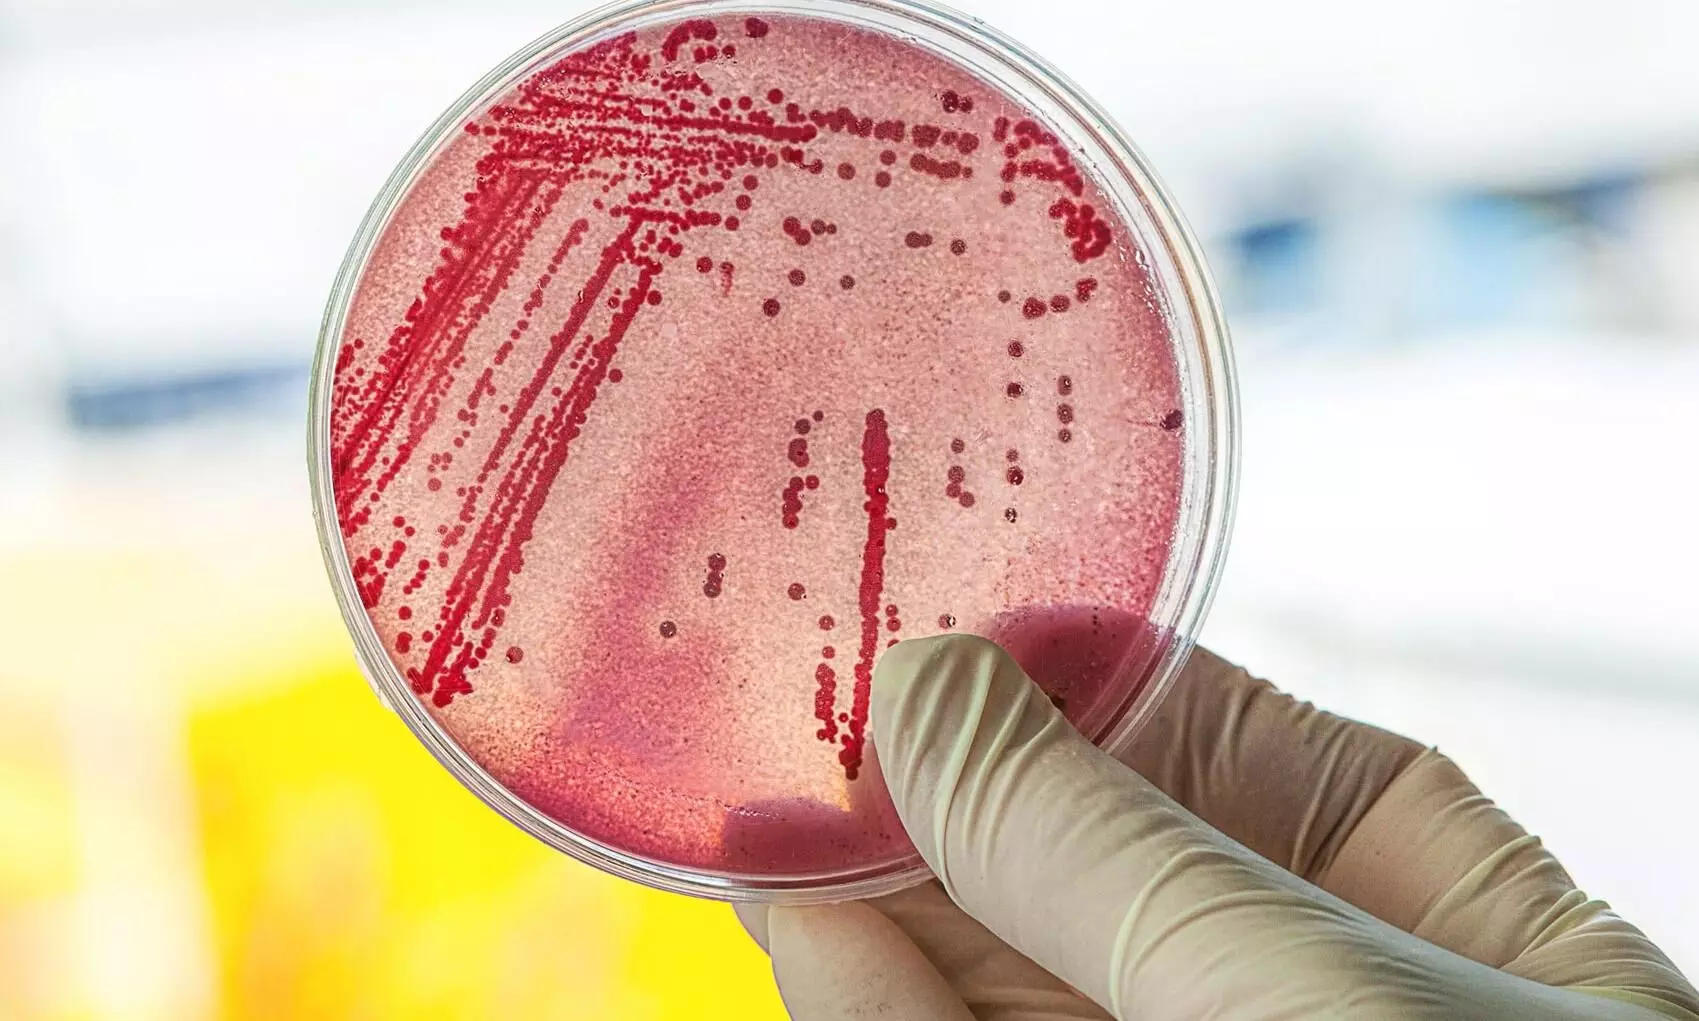
Coliform bacteria

കുടിവെള്ള സ്രോതസ്സുകൾ മലിനം: 70 ശതമാനത്തിലും കോളിഫോം ബാക്ടീരിയ സാന്നിധ്യം
text_fieldsതിരുവനന്തപുരം: ഗ്രാമീണമേഖലയിൽ കിണറുകളടക്കം കുടിവെള്ള സ്രോതസ്സുകളിൽ 70 ശതമാനത്തിലും കോളിഫോം ബാക്ടീരിയയുടെ സാന്നിധ്യമെന്ന് കണ്ടെത്തൽ. സംസ്ഥാന വ്യാപകമായി 401300 സാമ്പിളുകൾ ജലഅതോറിറ്റിയുടെ ക്വാളിറ്റി കൺട്രോൾ വിഭാഗം പരിശോധിച്ചപ്പോഴാണ് 280900 ഓളം സാമ്പിളുകളും കോളിഫോം ബാക്ടീരിയ മൂലം മലിനമാണെന്ന് കണ്ടെത്തിയത്. 2021 ഏപ്രിൽ-2022 മാർച്ച് കാലയളവിലായിരുന്നു പരിശോധന. ഭൂജലനിരപ്പ് താഴുന്നതാണ് ബാക്ടീരിയ സാന്നിധ്യം വർധിക്കുന്നതിനുള്ള പ്രധാന കാരണമായി ചൂണ്ടിക്കാട്ടുന്നത്. നേരിട്ടുള്ള സെപ്റ്റിക് മാലിന്യസാന്നിധ്യം മാത്രമല്ല, ഇലകളും മറ്റും കിണറുകളിൽ അഴുകുന്നതും കോളിഫോം ബാക്ടീരിയകളുണ്ടാക്കും. നിറത്തിലോ മണത്തിലോ വ്യത്യാസമില്ലെങ്കിലും ഇവയുടെ സാന്നിധ്യം ശാസ്ത്രീയ പരിശോധനകളിലൂടെയേ കണ്ടെത്താനാനാവൂ.
തിളപ്പിച്ച വെള്ളം ഉപയോഗിക്കുക എന്നതാണ് പ്രധാന പോംവഴി. മഴക്കാലത്ത് ഇവയുടെ സാന്നിധ്യം താരതമ്യേന കുറവാണ്. ഒറ്റപ്പെട്ട ചിലയിടങ്ങളിൽ അയൺ പോലുള്ള രാസമാലിന്യങ്ങളും കണ്ടെത്തിയിട്ടുണ്ട്. ഇതിന് പുറമേ കുടുംബശ്രീയുമായി സഹകരിച്ച് ഫീൽഡ് ടെസ്റ്റിങ് കിറ്റ് (എഫ്.ടി.കെ) ഉപയോഗിച്ചുള്ള മറ്റൊരു പരിശോധനയും പുരോഗമിക്കുന്നുണ്ട്. പി.എച്ച് മൂല്യം, അമോണിയ, അയൺ, നൈട്രേറ്റ്, സൾഫേറ്റ്, ബാക്ടീരിയ സാന്നിധ്യം എന്നിങ്ങനെ 12 കാര്യങ്ങളാണ് എഫ്.ടി.കെ സ്ട്രിപ്പ് ഉപയോഗിച്ച് കുടുംബശ്രീയുടെ സഹകരണത്തോടെ നടത്തുന്നത്. രാസമാലിന്യങ്ങളുടെ സാന്നിധ്യമുണ്ടോ എന്നതാണ് ഇതിലൂടെയുള്ള പ്രധാന പരിശോധന. ഇത്തരം മാലിന്യം കണ്ടെത്തുന്ന സ്ഥലങ്ങളിൽ നിന്ന് വീണ്ടും സാമ്പിളുകൾ ശേഖരിച്ച് എത്രയളവ് രാസമാലിന്യം വെള്ളത്തിലുണ്ട് എന്നത് കണ്ടെത്താൻ ലാബിൽ വിശദപരിശോധനക്ക് വിധേയമാക്കും. തുടർന്ന് ഇത്തരം മേഖലകളെ ജി.ഐ.എസ് മാപ്പിങ് (ജിയോഗ്രഫിക് ഇൻഫർമേഷൻ സിസ്റ്റം മാപ്പിങ്) നടത്താനും ജല അതോറിറ്റിക്ക് തീരുമാനമുണ്ട്.
കാടു മൂടിയ കിണറുകളിലും ഏറെക്കാലമായി മോട്ടോർ ഉപയോഗിക്കുന്നവയിലും ഡിഫോൾട്ട് ഓക്സിജന്റെ അളവ് കുറയുന്നതും ശ്രദ്ധയിൽപെട്ടിട്ടുണ്ട്. വെള്ളത്തിൽ 10 മില്ലിഗ്രാം പെർ ലിറ്റർ എന്നയളവിൽ ഡിഫോൾട്ട് ഓക്സിജൻ വേണമെന്നാണ് കണക്ക്. തൊട്ടിയും കയറും ഉപയോഗിക്കുന്നയിടങ്ങളിൽ ഇളക്കമുണ്ടാകുമെന്നതിനാൽ ഈ പ്രശ്നമുണ്ടാകാറില്ല.
Don't miss the exclusive news, Stay updated
Subscribe to our Newsletter
By subscribing you agree to our Terms & Conditions.